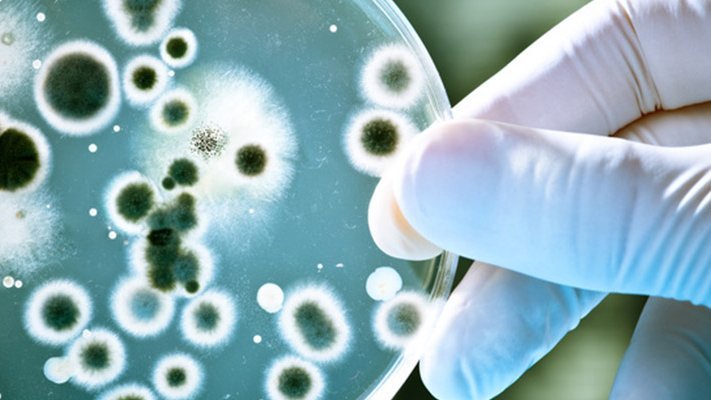
Es liegt was in der Luft … ein schutzbringender Duft Es liegt was in der Luft … ein schutzbringender Duft

Es liegt was in der Luft … ein schutzbringender Duft
Überall in unserer Umwelt findet man sie: Bakterien, Pilze und Co. Gerade in Krankenhäusern können dadurch vermehrt Infektionen auftreten. Wenn herkömmliche Reinigungsstrategien gegen die zum Teil multiresistenten Stämme erfolglos bleiben, kann die Verwendung von Aromaölen die Kontamination mit den Mikroorganismen eindämmen, zeigen die Ergebnisse einer italienischen Studie.
In Laborversuchen wurde die antimikrobielle Wirkung essentieller pflanzlicher Öle bereits nachgewiesen. In einem italienischen Krankenhaus mit zwei exakt gleich aufgeteilten Etagen wurde nun untersucht, ob eine Dispersion von Aromaöl in der Raumluft die Kontamination mit Bakterien und Pilzen auf den Oberflächen von Tischen, Schränken und Handläufen eindämmen und das damit verbundene Infektionsrisiko senken kann. Über einen Zeitraum von 5 Monaten wurde auf der einen Etage die gewohnte Sanitisierung mit den herkömmlichen Reinigungs- und Desinfektionsmitteln durchgeführt. Auf der anderen Etage wurde zusätzlich eine Aromaölmischung aus Lavendel, Cajeput, Sibirischer Tanne, Myrte und Zitronengeranie in der Raumluft verteilt. Hierzu wurde das Aromaöl jeden Tag nachts 8 Stunden lang bei geschlossenen Türen in zwei von acht Zimmern mittels Ultraschall-Vaporisator verdunstet. Tagsüber wurden die Türen aller Zimmer zum gemeinsamen Korridor geöffnet, um eine Luftzirkulation über den Flur und die anderen Räume zu erzielen.
Ätherische Öle
Zahlreiche Pflanzenporträts und viele Rezepturen aus der Aromatherapie – für Gesundheit und Wohlbefinden
Zahlreiche Pflanzenporträts und viele Rezepturen aus der Aromatherapie – für Gesundheit und Wohlbefinden
ISBN: 978-3-945150-93-1
Erscheinungsjahr: 2018
17,00 EUR
Zum Shop »Auf den Handläufen in den Korridoren konnten keine signifikanten Veränderungen hinsichtlich der bakteriellen Besiedelung verzeichnet werden. Die Arzneimittelverschreibungen, vornehmlich gegen Infektionen und Atemwegsprobleme, sowie die Dauer der erforderlichen Einnahmezeit lagen bei den Patienten auf der Aromaöl-Etage um 80 % bzw. 86 % niedriger als auf der Kontroll-Etage. Unerwünschte Wirkungen, wie allergische Reaktionen auf das Aromaöl traten bei keinem der Patienten auf.
Tipp:
Weitere Artikel und Videos zum Thema Aromaöle/Aromatherpie finden Sie hier:
www.carstens-stiftung.de/tag/aromatherapie
Einschätzung
Die Dispersion von antimikrobiell wirkenden essentiellen Pflanzenölen ist eine effektive Ergänzung zur herkömmlichen Sanitisierung in Krankenhäusern und Pflegeeinrichtungen. Wie die Studienergebnisse zeigen, wäre es jedoch erforderlich ebenfalls Flure und ggfs. Treppenhäuser mit dem Aromaöl zu behandeln bzw. für eine ausreichende Luftzirkulation und damit Verteilung der feinen Öltröpfchen auch in diese Bereiche zu sorgen. Besonders effektiv wird vermutlich die Reduktion der Keimzahlen auf allen horizontalen Flächen wie Tischen, Sitzflächen von Stühlen, Fensterbänken etc. sein, da die Öltröpfchen sich hier im Vergleich zu vertikalen Flächen vermehrt niederschlagen können. Trotz der positiven Ergebnisse in der vorliegenden Studie, sollte jedoch bei der Verwendung von Aromaölen Vorsicht walten hinsichtlich möglicher unerwünschter Reaktionen. Es sollten Öle mit geringem allergenem Potenzial wohldosiert eingesetzt werden. Ein weiterer Aspekt ist die Wirkung von Aromaölen auf die Psyche der Patienten sowie des Krankenhauspersonals. Auch hier sollte fachkundig unter den nachweislich antimikrobiell wirkenden Aromaessenzen gewählt werden.
Literatur
1) Gelmini F, Belotti L, Vecchi S, Testa C, Beretta G. Air dispersed essential oils combined with standard sanitization procedures for environmental microbiota control in nosocomial hospitalization rooms. Compl Ther Med 2016; 25: 113-119.Abstract
